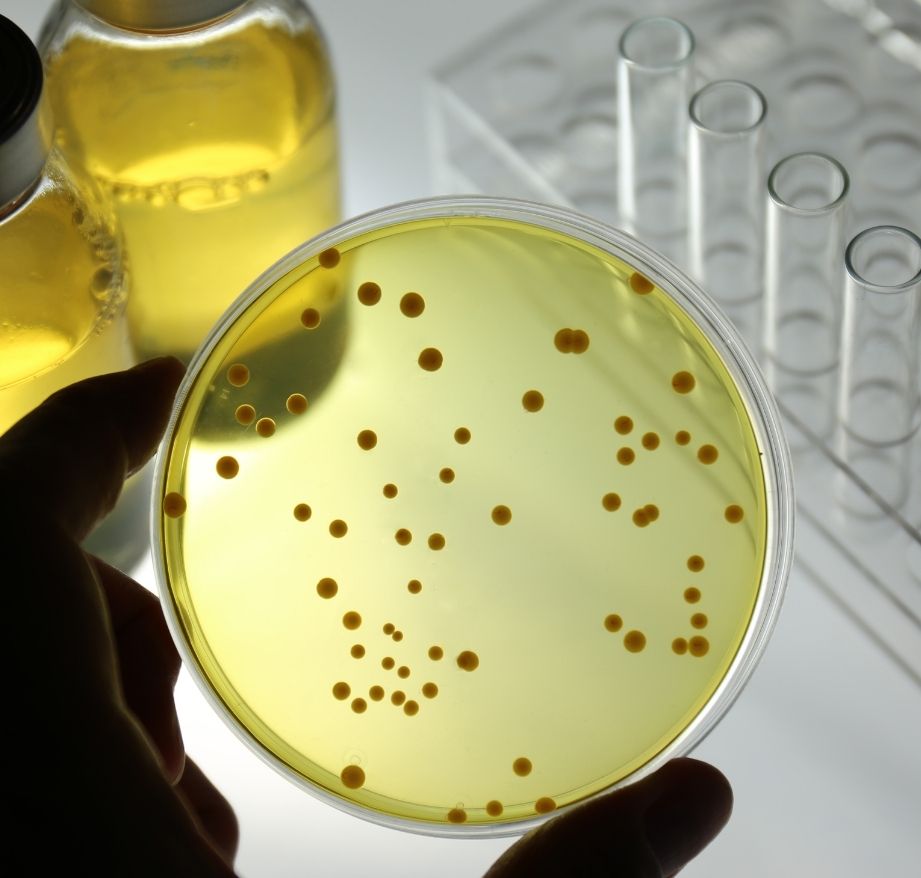

You receive clear, actionable reports along with expert guidance for next steps or revalidation
Trusted UK Laboratory for ISO Standard Microbiology Testing
From bespoke R&D for emerging SMEs to high-throughput routine testing for industry.
We provide technical rigor of a Tier-1 facility with the flexibility of a dedicated research partner.
Our lab provides accurate, fast, and comprehensive testing services. From routine to specialised diagnostics, we cover it all. Trusted by academia and industry alike, we deliver reliable results every time
Tailored microbiological studies designed to fit unique product applications.
Monitoring and assessing environmental hygiene across various surfaces and media.
Ensuring water safety and compliance through microbial contamination analysis.
Our controlled laboratory workflow ensures accurate, compliant microbiology results delivered efficiently from start to finish
We begin with a detailed discussion to understand your testing requirements, product type, and regulatory goals
You send your samples following our clear submission guidelines, ensuring safe handling
Our expert microbiologists conduct ISO-standard testing using validated and reliable methods
You receive clear, actionable reports along with expert guidance for next steps or revalidation
We provide microbiological testing for cosmetics, personal care, healthcare, biocides, veterinary, and environmental products. Our services cover both routine and bespoke testing needs
Yes, all our testing is conducted to internationally recognised ISO and EN standards, ensuring reliable, accurate, and globally accepted results
Turnaround times depend on the type of test, but we prioritize efficiency and provide estimated timelines during consultation to meet your project deadlines
Absolutely. We design bespoke testing programs tailored to your product, application, and regulatory requirements, including novel research and method development
Yes. We offer vegan-consumable testing, and support sustainable and ethical product development
Yes, we have extensive knowledge of UK, EU, and global regulatory frameworks, helping you meet both local and international standards
We provide clear, detailed reports with actionable insights, not just pass/fail data, enabling informed decisions for your business

Most large-scale labs are bound by rigid, pre-defined scopes. If your product is novel or your project is non-standard, they often can’t help.
At Orion, we operate out of the world-class Sci-Tech Daresbury campus. While we are currently progressing toward formal ISO accreditation, we already strictly adhere to ISO 17025 quality management systems.
This gives you the best of both worlds: the data integrity required for regulatory submission, combined with the flexibility to design custom protocols that “off-the-shelf” labs simply won’t touch.
We’ve worked with several labs over the years, but Orion stands out for their professionalism and flexibility. Their tailored testing approach saved us both time and cost while ensuring full compliance with healthcare standards.
The Orion team helped us validate our eco-friendly cleaning range efficiently. They understood our sustainability goals and provided vegan-consumable testing, which was crucial for our brand certification. Highly recommended!
Reliable, precise, and science-driven. Orion Microbiology provided excellent veterinary microbiology testing and clear communication throughout the process. Their expertise truly adds value to our research.
Orion Microbiology has been an exceptional partner for our cosmetic testing needs. Their team is highly responsive, knowledgeable, and always delivers results on time. The clarity of their reports helps us move forward with confidence.